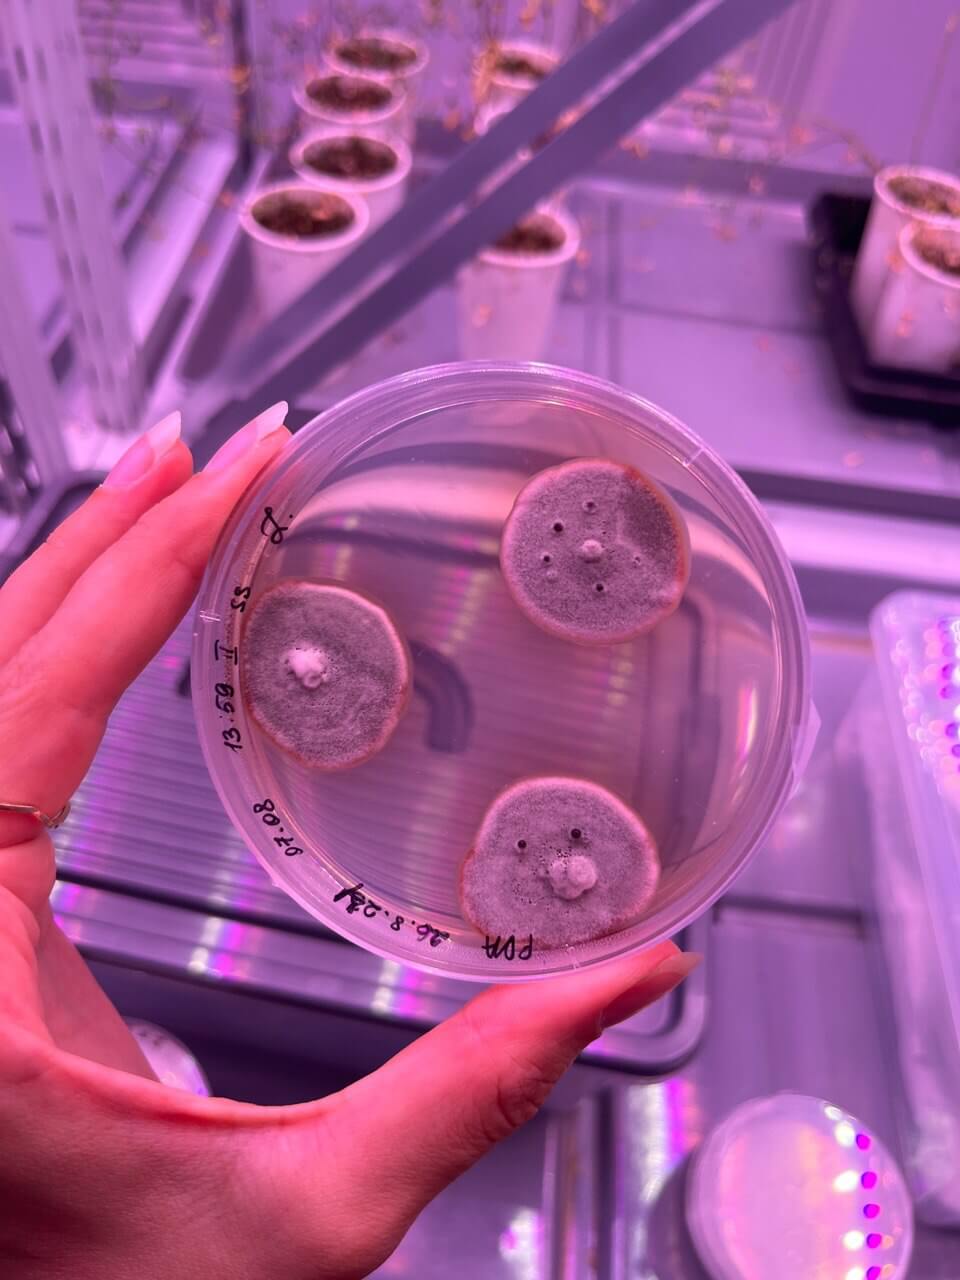

База для разработки препаратов
Для пополнения существующих коллекций фитопатогенов и насекомых-вредителей отдел биологических испытаний компании организовал экспедицию для их сбора в различных регионах России и Беларуси. В работе приняли участие сотрудники региональных представительств «Августа» в Орловской области, Республике Мордовия и Ставропольском крае, агроконсалтинговых лабораторий в Ливнах, Грязях, Саранске, Азове и Ставрополе, а также специалисты Белорусского НИИ защиты растений.
Научный сотрудник отдела инсектицидов Дарья Орел в одной из экспедиций
О задачах, поставленных перед участниками экспедиции, и их результатах рассказывают старший научный сотрудник группы испытания фунгицидов Елена Алексеевна ВОЛЫНЧИКОВА и старший научный сотрудник группы испытания инсектицидов Ольга Геннадьевна ГРИБОЕДОВА.
В КОЛЛЕКЦИЮ ПАТОГЕНОВ
Е. А. Волынчикова: «Группа фунгицидов, созданная в августе 2023 года, смогла заложить базис коллекции благодаря растительным образцам, предоставленным коллегами из регионов. На этих фитопатогенных организмах мы провели скрининг нескольких десятков новых химических соединений, которые в перспективе смогут войти в линейку препаратов «Августа».
В этом году был развернут полномасштабный отбор растений с разнообразными симптомами заболеваний для формирования наиболее полной коллекции грибных объектов с учетом географического разнообразия фитопатогенов. В зависимости от климатических особенностей, а также различий в агрономических подходах изоляты из разных регионов могут сильно различаться по степени их агрессивности, а также демонстрировать различную степень устойчивости к фунгицидам, что напрямую определяет целесообразность применения конкретных препаратов.
Колонии гриба Cercosрora beticola
Наличие разнообразных изолятов в коллекции позволяет максимально реалистично воспроизводить актуальную фитопатологическую обстановку и предсказывать, как фунгициды будут работать в отношении как чувствительных, так и резистентных грибов. Особенно такие испытания нужны для новых препаратов. Помимо этого, широкая коллекция тест-объектов позволяет на основании лабораторных испытаний подобрать наиболее точную, эффективную и актуальную схему контроля заболеваний в полях.
Анализ отобранных образцов сигнализирует о доминировании в нынешнем сезоне нескольких заболеваний. На растениях картофеля замечено преобладание альтернариозной и антракнозной инфекций, причем последняя распространена на всех органах растения от листьев до клубней. Контроль такого комплексного заболевания может быть значительно затруднен при неправильном выборе препарата. Даже при наличии широкой линейки фунгицидов «Августа» для защиты картофеля, окончательный выбор препарата должен быть сделан на основе тщательного и корректного определения микробного агента, вызывающего заболевание.
На растениях свеклы в регионах с умеренно континентальным климатом была отмечена большая степень поражения церкоспорозом. На некоторых образцах зафиксирована резистентность к применяемым препаратам, поэтому мы планируем провести масштабный скрининг для определения фунгицидов, которые смогут подавлять развитие заболевания, вызываемого природными популяциями гриба Cercospora. Помимо этого, широкая линейка церкоспорных агентов из различных регионов в коллекции позволит разработать новые препараты для подавления резистентных форм.
Важность применения химических обработок плантаций земляники была отмечена в одном из хозяйств Мордовии. Их отсутствие привело к развитию там сложного комплекса разнообразных заболеваний. В лаборатории были диагностированы и выделены патогены, вызывающие корневые гнили, листовые пятнистости и антракноз: Colletotrichum, Fusarium, Pestalotiopsis, Phomopsis и Ramularia. Формирование такого комплекса опасно по двум причинам: во-первых, практически невозможно подобрать препарат, который сможет одновременно подавлять все фитопатогены сразу. А увеличение количества фунгицидов неизбежно ведет к появлению резистентных популяций патогенов, что в долгосрочной перспективе означает потерю эффективности этих препаратов. Во-вторых, развитие комплексных заболеваний на одной территории включает риск их распространения в соседние хозяйства».

Лист земляники, пораженный пятнистостью
В «КОПИЛКУ» ВРЕДИТЕЛЕЙ
О. Г. Грибоедова: «Для непрерывного процесса тестирования новых действующих веществ и препаративных форм инсектицидов необходимо круглогодичное разведение насекомых-вредителей в лаборатории. Для этого нужно собрать и поддерживать коллекцию экономически наиболее значимых для сельского хозяйства членистоногих.
На полях рапса в Орловской области и в Республике Мордовия собрали капустную моль Plutella xylostella и капустную совку Mamestra brassicae, а на картофеле – колорадского жука Leptinotarsa decemlineata. Из хозяйств Тульской области привезли представителей популяции колорадского жука с предполагаемой устойчивостью к неоникотиноидам. Эти насекомые – представители отрядов Чешуекрылые и Жесткокрылые – прекрасные модельные объекты для испытания инсектицидов, предназначенных против насекомых с грызущим ротовым аппаратом.
Коллекцию вредителей пополнили кукурузный мотылек Ostrinia nubilalis, выявленный в Беларуси и Ставропольском крае, сейчас вводим его в лабораторную культуру, а также помидорная совка (карадрина) Spodoptera exigua из Ростовской области, обнаруженная в посевах сахарной свеклы.
В инсектарии уже находится представитель семейства настоящих тлей – обыкновенная злаковая тля Schizaphis graminum. Для коллекции насекомых с сосущим ротовым аппаратом мы разводим в лаборатории собранную в Мордовии гороховую тлю Acyrthosiphon pisum. Однако испытывать различные препаративные формы инсектицидов нужно на непохожих друг на друга растениях, как, например, горох и пшеница. Для этого коллекция насекомых в научном центре должна содержать достаточное количество видов для моделирования разных систем «насекомое - растение», поэтому в следующем сезоне мы планируем продолжить экспедиции».

Колонии гриба Paraphomopsis, вызывающего пятнистость на листьях земляники – предположительно P. obscurans
Чтобы совершенствовать и развивать продуктовую линейку «Августа», необходима система обратной связи между полем и наукой. Не менее важно вести мониторинг распространения и миграции фитопатогенов и насекомых вредителей, появления их резистентных к ХСЗР форм, которые нужно вводить в коллекцию и использовать для испытаний новых д. в. и препаративных форм. Собранную информацию НИЦ планирует в дальнейшем предоставлять клиентам в виде аналитических выкладок и прогнозов.
Материал подготовил Владимир БОНДАРЕНКО, начальник отдела биологических испытаний «Августа»
Фото из архива отдела
Контактная информация
Владимир Сергеевич БОНДАРЕНКО
+7 (495) 787-08-00, доб. 1662
Елена Алексеевна ВОЛЫНЧИКОВА
+7 (495) 787-08-00, доб. 2326
Ольга Геннадьевна ГРИБОЕДОВА.
+7 (495) 787-08-00, доб. 1288
Перепечатка и копирование материалов на электронные ресурсы только с письменного разрешения редакции и с указанием первоисточника.